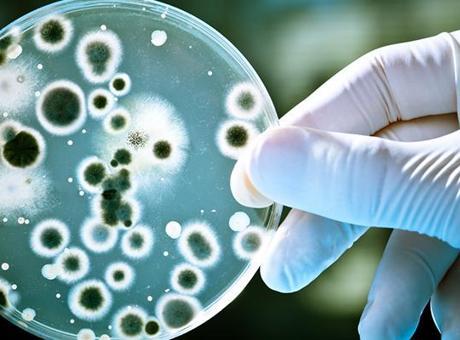

Bilim dünyasında çığır açan buluş! Yapay zeka, bakterileri yok eden virüs üretti
Stanford Üniversitesi ve merkezi ABD'de bulunan Arc Enstitüsünden araştırmacılar, antibiyotiklere karşı giderek güçlenen bazı bakteri türlerine karşı yeni tedavi bulmak umuduyla çalışma yaptı.
Bilim insanları, yapay zeka modellerini kullanarak "bakteriyofaj" adı verilen ve bakterileri enfekte eden virüslerin genetik planlarını sıfırdan tasarladı.
CANLI BAKTERİLERİ YOK EDEBİLİYOR
Laboratuvar deneylerinde tasarlanan yüzlerce virüs arasından 16'sının canlı bakterileri yok edebildiği görüldü. Çalışmanın sonucunda bu virüslerden bazıları, doğada bulunan benzerlerinden daha hızlı ve etkili sonuç verdi.
DİRENÇLİ TÜRLERDE DE ETKİLİ
Araştırmacılar, yapay zeka ile tasarlanan bakteriyofaj virüslerini bir araya getirerek hazırladıkları "karışımın", bazı dirençli bakteri türlerini kısa sürede etkisiz hale getirdiğini tespit etti.
Çalışmayı yürüten ekip, bu yöntemin sadece bakteriyel enfeksiyonlarla mücadelede değil gelecekte daha karmaşık biyolojik sistemlerin tasarımında da kullanılabileceğini belirtti.
E.coli, insan ve hayvan bağırsaklarında doğal olarak bulunan bakteri türüdür. Çoğu türü zararsızdır ve sindirime yardımcı olur ancak bazen ishal, idrar yolu enfeksiyonu veya nadiren daha ciddi hastalıklara yol açabilir. Araştırmanın sonuçları, "BioRxiv" internet sitesinde yayımlandı.
